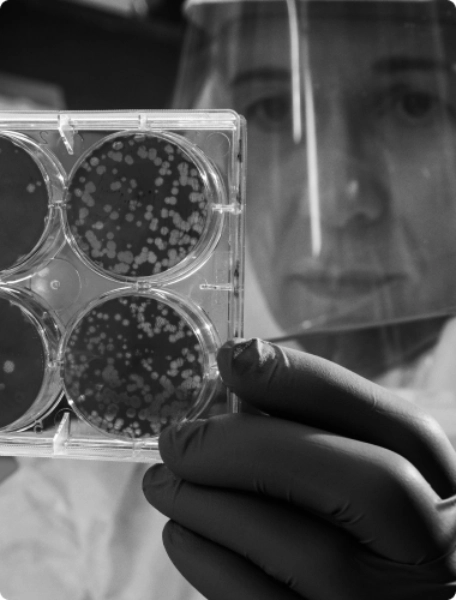

The Hidden Health Crisis: Why Your Blood Vessels Are Aging Faster Than You Think
Leading researchers are shedding new light on one of the body’s most powerful yet overlooked molecules: nitric oxide. This simple compound, consisting of just one nitrogen and one oxygen atom, may hold the key to transforming how we approach cardiovascular health, cognitive function, and overall vitality.